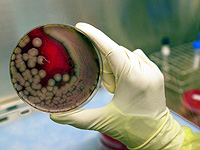
Гигантские вирусы поражают водоросли в мировом океане

Наука и Хайтек
adv_09 rimma_dw_d
adv_10 rimma_dw_m
adv_11 ca_instrip_direct
adv_12 ca_instrip_direct
Наука и Хайтек ::
5 Октября 2024 г.